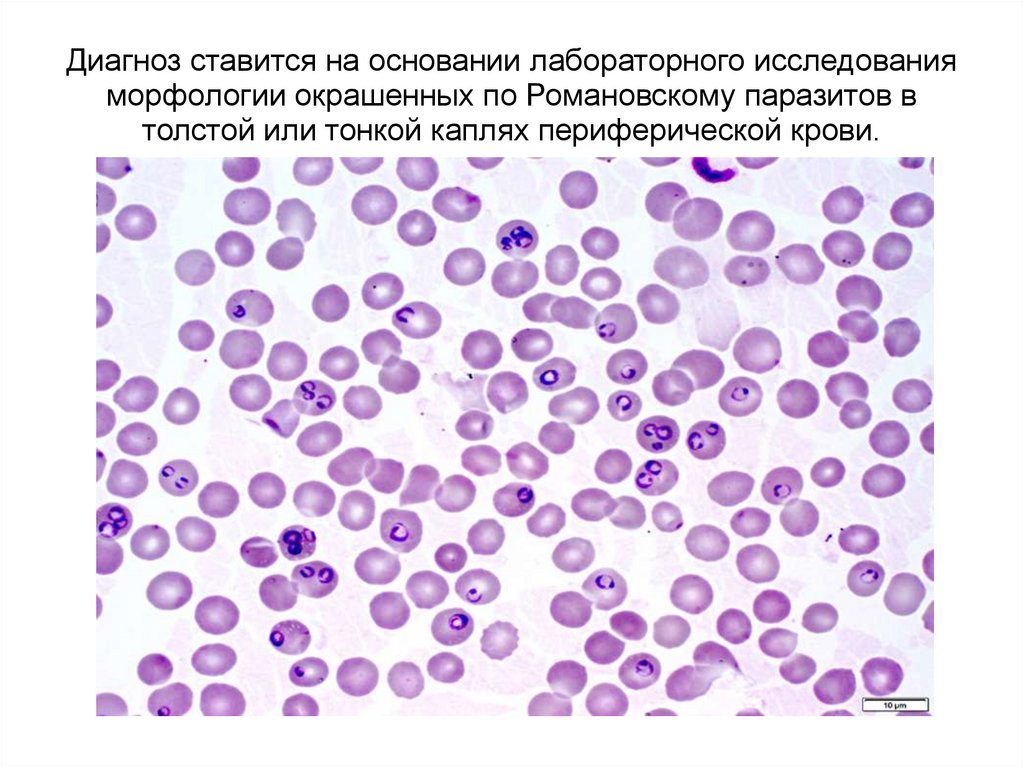

Similar presentations:
Занятие 3. Споровики-1
1.
Тема 3. ПРОСТЕЙШИЕ PROTOZOAТИП СПОРОВИКИ SPOROZOA
КЛАСС КОКЦИДИЕОБРАЗНЫЕ
COCCIDIOMORPHA
2.
Тип споровики (апикомплексы) - простоорганизованные простейшие ведущих
паразитический образ жизни внутри клеток
хозяина.
Паразиты имеют округлую или овальную
форму, пищеварительные и сократительные
вакуоли, органоиды передвижения
отсутствуют.
Ферментативная система паразитов
редуцирована, характерно использование
метаболических путей хозяина.
3.
Малярийные плазмодии4 вида способны причинить вред человеку:
Pl. falciparum
Pl. vivax
Pl. ovale
Pl. malariae
Промежуточный хозяин (резервуар) — человек
(в его теле
происходит шизогония)
Окончательный хозяин (переносчик) - самка
комара из рода Anopheles (в её теле
4.
Plasmodium vivax – возбудитель трехдневноймалярии, обитает повсеместно, даже на
территориях с умеренным климатом (юг
Европы).
Plasmodium falciparum – возбудитель
тропической малярии (самой
злокачественной с церебральными
осложнениями), встречается только в
тропиках и субтропиках.
Plasmodium malariae – возбудитель
четырехдневной малярии (с осложнениями
на почки), встречается там же, где и два
предыдущих вида, только более редко.
Plasmodium ovale – возбудитель овале
5.
6.
7.
Вместе с поглощенной кровью в желудок самкикомара попадают эритроциты с ♀ и ♂
гамонтами, которые вскоре формируют
гаметы. После их слияния образуется зигота
(оокинета) и внедряется в стенку желудка.
Там она становится ооцистой, внутри
происходит
деление
и
формируются
спорозоиты – инвазионная для человека
стадия.
Попадая в организм здорового человека при
укусе комара, спорозоиты проникают в кровь
и движутся к печени, где в течение двух
недель в её клетках наблюдается тканевая
(экзоэритроцитарная) шизогония. При этом
спорозоиты становятся трофозоитами, а
8.
9.
10.
Диагноз ставится на основании лабораторного исследованияморфологии окрашенных по Романовскому паразитов в
толстой или тонкой каплях периферической крови.
11.
Стадии развитияPlasmodiumvivax.
12.
13.
Токсоплазма (Toxoplasma gondii)Облигатный
внутриклеточный
паразит
позвоночных,
вызывающий
антропозоонозное
заболевание
токсоплазмоз.
Окончательный
хозяин
и
природный
резервуар - представители семейства
Кошачьи (Felidae), чаще домашние кошки.
Промежуточные хозяева - различные виды
грызунов,
птицы,
крупный
и
мелкий
домашний скот, а также человек.
Распространение — повсеместно.
14.
15.
16.
17.
18.
Жизненный цикл токсоплазмы19.
В эпителиальных клетках кишечника кошкипаразит размножается шизогонией, затем
образует гаметы, начинается спорогония.
В окружающую среду выделяются незрелые
ооцисты, спорозоиты, которые заканчивают
развиваться только на воздухе.
В
организмах
промежуточных
хозяев
токсоплазма совершает циклы бесполого
размножения
(шизогония)
и
образует
истинные или ложные цисты (псевдоцисты).
20.
Заражение человека токсоплазмозомпроисходит несколькими путями:
1) алиментарным путем при проглатывании
непрожаренного мяса, фарша, содержащих
истинные или ложные цисты, при
употреблении некипяченого молока и сырых
яиц;
2) пероральное попадание ооцист с
загрязненных кошачьими фекалиями рук;
3) при переливании крови или трансплантации
органов;
21.
Различают две клинические формытоксоплазмоза: врожденный и
приобретенный.
Врожденный токсоплазмоз наблюдается у
плода, инфицированного
паразитом через плаценту от матери. При этом
наблюдаются серьезные врожденные
патологии развития (например,
гидроцефалия), иногда имеют место
спонтанные аборты пораженных плодов или
невынашивания беременности.
Приобретенный токсоплазмоз у
большинства людей с нормально
работающей иммунной системой протекает
22.
Лабораторная диагностика — мазки крови,спинномозговой
жидкости,
пунктатов
лимфоузлов,
плаценту
или
трупный
материал.
Если необходимо установить, переболел ли
человек
токсоплазмозом,
является
ли
носителем паразита или болеет в данный
момент, проводят анализ на содержание
определенных антител в крови.
Профилактика
токсоплазмоза
предусматривает
соблюдение
правил
содержания кошек, термическую обработку
мяса и других продуктов питания животного
происхождения,
обязательное
мытье
23.
Пневмоциста – возбудительпневмоцистоза
Пневмоциста имеет овальную форму, размеры
2 – 3 мкм, окружена слизистой капсулой.
Источниками заражения человека являются
больные пневмоцистозом люди, собаки,
овцы, грызуны.
Путь передачи – воздушно-капельный, иногда
трансплацентарный.
Пневмоцисты локализуются в альвеолах
легких, вызывая хроническую пневмонию.
Лабораторная диагностика основана на
обнаружении вегетативных форм и
24.
Саркоциста – возбудительсаркоцистоза
Саркоциста сходна с токсоплазмой.
Цикл развития состоит из шизогонии,
протекающей в мышцах промежуточного
хозяина (крупный рогатый скот, свиньи, редко
человек). Образуются цисты, имеющие вид
мешковидного образования, состоящего из
скопления мерозоитов.
Окончательными
хозяевами
саркоцисты
являются собаки, кошки, а также человек,
которые заражаются при поедании сырого
или плохо термически обработанного мяса.

medicine
medicine








